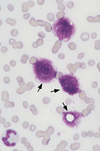

Blastomycosis may be disseminated in dogs, but which of the following is most frequently the primary site of involvement?
A) Intestine
B) Liver
C) Lungs
D) Nasal cavity
E) Spleen
C) Lungs
A 5YO female West Highland White Terrier dog is brought back to the clinic ten days after being diagnosed as having pyoderma. Physical examination at the time had shown papule, pustules, and epidermal collarettes predominantly distributed in the inguinal region. A two-week course of trimethoprim-sulfadiazine at a standard dose was prescribed, and the client reported clearing of the lesions within a few days. The dog has now developed spreading, circular, bull’s-eye, erythematous lesions on the thorax and forelimbs. There are some papules but no erosion or ulceration. A skin biopsy is obtained. Which of the following is the most appropriate next step pending results of the skin biopsy?
A) Administer oral prednisone
B) Change medication to cephalexin
C) Change medication to itraconazole
D) Continue current therapy
E) Discontinue all therapy
E) Discontinue all therapy
SIGN OF DRUG HYPERSENSITIVITY OR IMMUNE REACTION; best to wait for biopsy results!
A 13-year-old cat has a large, firm mass of the third mammary gland on the right side. Which of the following represents the likelihood that this tumor is malignant?
A) 10%
B) 25%
C) 40%
D) 60%
E) 90%
E) 90%
A 4-year-old neutered male cat is in shock two hours after sustaining a small wound in the left flank and a larger wound on the lower right side just caudal to the 13th rib. A projectile injury is suspected. Which of the following conditions is most likely to result from these injuries?
A) Peritonitis
B) Pneumomediastinum
C) Pneumothorax
D) Pyothorax
E) Spinal fracture
A) Peritonitis
**NOTE, the wound is CAUDAL to the last/13th rib, so peritonitis is the only answer NOT in the thorax that makes sense!
At the present time, which of the following is the most effective management for eradication of brucellosis in cattle?
A) Serologic identification and vaccination of infected animals
B) Serologic identification of infected animals followed by isolation and slaughter
C) Vaccination of all animals as calves
D) Vaccination of all animals that had no detectable serologic titer
E) Vaccination of all susceptible animals as calves and before pregnancy
B) Serologic identification of infected animals followed by isolation and slaughter
A 3-year-old Percheron mare is undergoing routine dental evaluation. Physical examination shows bilateral prolapse of the nictitating membrane and muscle fasciculations of the neck, shoulders, and flank. During examination, the mare’s hindlimb give way, and she leans back in a dog-sitting posture. Rectal temperature is 100.4 F, heart rate is 60 beats/min, and respiratory rate is 30 breaths/min. Laboratory studies show:
Which of the following is the most likely diagnosis?
A) Equine degenerative myelopathy
B) Equine motor neuron disease
C) Exertional rhabdomyolysis
D) Hyperkalemic periodic paralysis
E) Tetanus

D) Hyperkalemic periodic paralysis
A 10-year-old spayed female cat is being evaluated because of a suspected injury to both hindlimbs. The cat has been drinking and urinating excessively for the past two months. She is walking in a plantigrade stance. What is the most likely cause of this stance?
A) Bilateral Achilles tendon injury
B) Diabetes mellitus
C) Hyperadrenocorticism
D) Hyperthyroidism
E) Lumbar intervertebral disk disease
B) Diabetes mellitus
A 10-year-old commercial beef cow has had a gradually diminished appetite and progressive weight loss over the past 2 months. Feces are dry and scanty. She continues to drink water. Physical examination shows distention of the left paralumbar fossa and ventral right abdominal wall. On rectal palpation, the rumen is full of firm ingesta and the ventral sac extends to the right of midline (L-shaped). Which of the following is the most appropriate next step?
A) Administration of bismuth subsalicylate with sucrose
B) Administration of magnesium hydroxide
C) Exploratory laparotomy
D) Salvage to slaughter
E) Surgical creation of rumen fistula
D) Salvage to slaughter
likely TYPE I OR II VAGAL INDIGESTION, and for an older COMMERICAL BEEF COW best to SLAUGHTER
An 82-lb (37-kg), 8-year-old male German Shepherd mixed-breed dog is being evaluated because of a two-month history of decreased exercise tolerance. The client reports that the dog had two episodes of “profound weakness” on walks during the past week. The dog seems comfortable at home, but his “heart is racing all the time.” Two years ago, another veterinarian diagnosed the dog with hypothyroidism and prescribed oral levothyroxine 0.8 mg twice daily. Dosage was reevaluated one month after initiation of treatment and was determined appropriate. Appetite, urination and bowel movements are normal. Body condition score is 6/9. Temperature is 101.2 F and heart rate is 180 beats/min. The dog is panting. Physical examination detects a pulse deficit that occurs three to five times each minute. No other abnormalities are noted. Results of the complete blood count, serum biochemistry profile, and urinalysis are within normal limits. Which of the following is the most likely explanation for the episodic weakness in this dog?
A) Decreased cardiac output
B) Electrolyte imbalance
C) Neurogenic weakness
D) Osteoarthritis
E) Ventilation-perfusion mismatch
A) Decreased cardiac output
A 10-year-old dog has had difficulty walking for the past week. Findings on physical and neurologic examinations include hypermetria and a decreased hopping reflex in the left fore- and hindlimbs. A lesion is most likely to be found on which of the following structures of the nervous system?
A) Left brainstem
B) Left cerebellum
C) Left cerebrum
D) Right brainstem
E) Right cerebellum
B) Left cerebellum
Fifteen of a group of 200, 7-month-old feedlot calves are lame. The calves arrived at the feedlot approximately one month ago, and one week later 4 of the animals developed pneumonia. These calves were treated with oxytetracycline, and the pneumonia appeared to resolve. On physical examination, the affected calves have swellings in the carpi, tarsi and stifles with distention of associated tendon sheaths, and a stiff gait. Two calves are euthanized. Postmortem examination shows fibrinous pleuritic and papillary muscle necrosis. Which of the following organisms is the most likely cause of these signs?
A) Arcanobacterium (Actinomyces) pyogenes
B) Histophilus somni (Haemophilus somnas)
C) Mannheimia (Pasteurella) haemolytica
D) Pasteurella multocida
E) Salmonella typhimurium
B) Histophilus somni
SIGNS = pleuritis on necropsy, muscle stiffness, abx tx can cause more chronicity, spread via nasal and urogenital secretions
The radiograph is shown from a 6-year-old spayed female Yorkshire Terrier dog that is evaluated because of hematuria. Urine pH is 6.0. Which of the following is most likely the composition of the calculus?
A) Calcium oxalate
B) Cystine
C) Silica
D) Urate
E) Xanthine
A) Calcium oxalate
In a mare, a 30-day pregnancy is most likely detected on rectal examination by which of the following?
A) Absence of ovarian follicles
B) Palpation of the chorionic vesicle
C) Palpation of the corpus luteum
D) Palpation of the fetus
E) Slipping of the fetal membranes
E) Slipping of the fetal membranes
A 7-year-old castrated male Thoroughbred horse has a three-week history of intermittent cough associated with eating, unilateral (left-sided) Horner’s syndrome, and intermittent, bilateral, green-tinged nasal discharge. Two days ago, the horse bled profusely from the left nostril. Which of the following is the most likely source of hemorrhage?
A) Ethmoid hematoma
B) Internal carotid artery
C) Maxillary sinus mucosa
D) Maxillary vein
E) Nasal turbinates
B) Internal carotid artery
likely GUTTURAL POUCH MYCOSIS, causes SYMPATHETIC NERVE DAMAGE, DYSPHAGIA and INTERNAL CAROTID ARTERY bleeds!
Which of the following is the most common form of inflammatory bowel disease in cats?
A) Eosinophilic gastroenteritis
B) Lymphocytic-plasmacytic enterocolitis
C) Neutrophilic enteritis
D) Regional granulomatous enterocolitis
E) Small intestine bacterial overgrowth
B) Lymphocytic-plasmacytic enterocolitis
A 4-year-old second-lactation Holstein cow that is 150 days in milk has been in anestrus since calving. On palpation of the rectum, a cystic structure that is 3 cm in diameter is identified on the left ovary. Administration of which of the following is the most appropriate initial treatment?
A) Follicle-stimulating hormone followed by gonadotropin-releasing hormone in 15 days
B) Gonadotropin-releasing hormone followed by prostaglandin in 15 days
C) Melengestrol acetate followed by prostaglandin in 19 days
D) Prostaglandin followed by melengestrol acetate in 19 days
B) Gonadotropin-releasing hormone followed by prostaglandin in 15 days
A 7-year-old intact male llama is evaluated because of a two-day history of poor appetite and hypersalivation. The llama is kept on a backyard pasture with a 20-year-old horse. The horse also has had a poor appetite for the past two days. The animals’ diet consists of free choice access to the pasture and a trace mineral salt block and grass hay twice daily. Temperature of the llama is 104.5 F, heart rate is 90 beats/min, and respiratory rate is 40 breaths/min. Physical examination shows mild dehydration. Oral examination discloses two circular erosions of the lingual epithelium measuring approximately 1.5 cm in diameter. Temperature of the horse is 103.7 F, heart rate is 48 beats/min, and respiratory rate is 20 breaths/min. Oral examination of the horse discloses a solitary, circular erosion of the epithelium on the inside of the upper lip measuring 2 cm in diameter. Which of the following is the most likely diagnosis?
A) Contagious ecthyma
B) Equine herpesvirus 1 encephalomyelitis
C) Equine viral arteritis
D) Food-and-mouth disease
E) Vesicular stomatitis
E) Vesicular stomatitis
A flock of 8-week-old broiler chickens has a high condemnation rate at the processing plant because of lymphoid tumors in multiple organs. Which of the following is the most appropriate first question to ask the owner to determine the cause of the problem?
A) Did the feed contain mycotoxins?
B) Was the litter treated with chemicals?
C) Were any medications administered during grow out?
D) What is the genetic line of origin?
E) What is the vaccination history?
E) What is the vaccination history?
MAREK’S DISEASE
A group of 6- to 10-week-old lambs and their dams have crusted, proliferative lesions on the lips. Physical examination shows underlying crusts consisting of raised granulation tissue. There are no lesions on the buccal or lingual mucosa. The majority of lambs are affected, but only 5% of adult sheep are affected. Affected lambs are active and are nursing. The only adult goat on the farm has similar lesions. The horses, cattle, and pigs on the farm are unaffected. Which of the following is the most appropriate management?
A) Addition of organic iodine to trace mineralized salt
B) Oral administration of griseofulvin
C) Parenteral administration of oxytetracycline
D) Parenteral administration of procaine penicillin G
E) Observation
E) Observation
CONTAGIOUS ECTHYMA (orf) PARAPOXVIRUS that is MILD AND SELF-LIMITING
HIGHLY CONTAGIOUS IN YOUNG ANIMALS
Approximately 10% of the piglet litters in the farrowing rooms of a swine farm have mild, watery-to-pasty diarrhea. The manager of the farm reports that this diarrhea is low, but dehydration and a poor growth rate lead to lower weaning weights. Treatment with gentamicin has been ineffective, so the manager does not treat the piglets for the diarrhea. Which of the following is the most likely causal agent?
A) Circovirus
B) Parvovirus
C) Porcine enterovirus
D) Rotavirus
E) Transmissible gastroenteritis virus
D) Rotavirus
A 12-year-old spayed female Persian cat is evaluated because of a one-week history of anorexia, vomiting, polyuria, and polydipsia. Body condition score is 3/9. Physical examination shows lethargy and enlarged, irregular kidneys bilaterally. Serum studies show:
Which of the following is the most likely cause of these findings?
A) Bacterial cystitis
B) Chronic interstitial nephritis
C) Diabetes mellitus
D) Polycystic kidney disease
E) Transitional cell carcinoma

D) Polycystic kidney disease
A 2-year-old male Golden Retriever vomited food and bile-stained material shortly after eating eight hours ago. On physical examination, the dog is bright, alert, and well hydrated. Findings on abdominal palpation are normal. Which of the following is the most appropriate initial step in management?
A) Administer fluids intravenously for 24 hours and withhold food and water
B) Obtain a complete blood count, serum biochemistry profile, and urinalysis
C) Perform an upper gastrointestinal series with barium
D) Test a fecal sample for parvovirus
E) Withhold food and water for 24 hours and gradually reintroduce water and highly digestible foods
E) Withhold food and water for 24 hours and gradually reintroduce water and highly digestible foods
A 6-year-old Thoroughbred gelding was involved in a motor vehicle collision while riding in a trailer three weeks ago. Physical examination shows healing superficial abrasions on the face. A photograph of the horse is shown. Injury to which of the following nerves is the most likely underlying cause of these findings?
A) Left facial (VII) nerve
B) Right facial (VII) nerve
C) Left trigeminal (V) nerve
D) Right trigeminal (V) nerve
E) Left infraorbital nerve
F) Right infraorbital nerve

B) Right facial (VII) nerve
A group of 1000 5-week-old pigs has experienced a 2% death loss since weaning two weeks ago. Most of the deaths were sudden, however, approximately 3% of the pigs showed clinical signs of lethargy, lameness, and labored breathing before dying. Postmortem examination of an affected pig shows severe fibrinous pleuritis, pericarditis and peritonitis. Which of the following is the most likely causal organism?
A) Arcanobacterium suis
B) Escherichia coli
C) Haemophilus parasuis
D) Salmonella choleraesuis
E) Streptococcus suis
C) Haemophilus parasuis